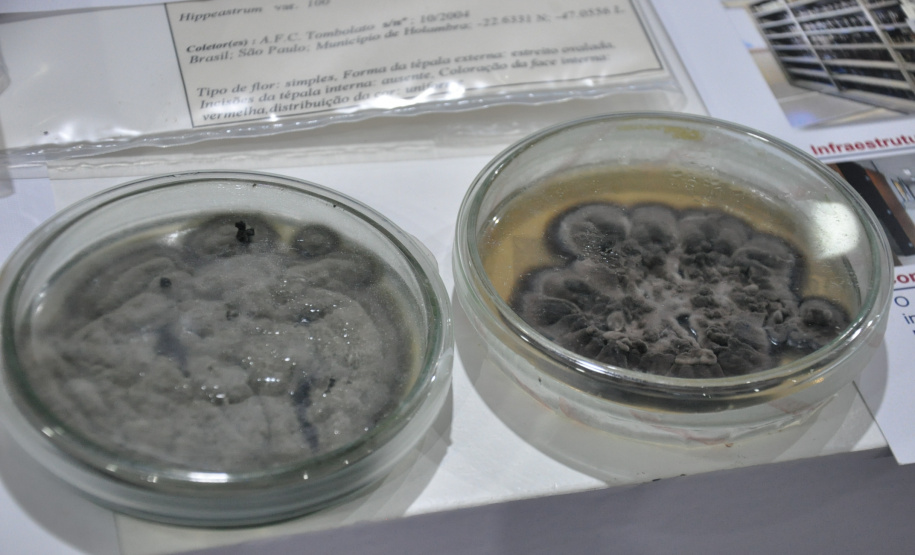
Governo do Estado apresenta ações de fomento científico e tecnológico  focadas na pesquisa

O Governo do Estado participou nesta terça-feira (25) de uma sessão especial da 5ª Conferência Nacional de Ciência, Tecnologia e Inovação (CNCTI), com foco em avaliação e financiamento de pesquisas. O evento integrou a programação da 75° Reunião Anual da Sociedade Brasileira para o Progresso da Ciência (SBPC), que acontece em Curitiba até o próximo sábado (29), com participação de milhares de acadêmicos, entre estudantes, professores e pesquisadores de todo o Brasil.
Ao lado de representantes do Conselho Nacional de Desenvolvimento Científico e Tecnológico (CNPq), do Conselho Nacional das Fundações Estaduais de Amparo à Pesquisa (Confap) e da Fundação de Amparo à Pesquisa do Estado do Rio de Janeiro (Faperj), o diretor de Ciência, Tecnologia e Inovação da Fundação Araucária, Luiz Marcio Spinosa, destacou os instrumentos de fomento científico do Paraná.
Em um auditório com pesquisadores de vários estados brasileiros, o gestor enfatizou o projeto Rotas Estratégicas dos Ecossistemas Regionais de Ciência, Tecnologia & Inovação (CT&I), que mapeou as vocações regionais voltadas ao desenvolvimento sustentável; a plataforma digital iAraucária - bancos de dados com informações sobre produções científicas e pesquisadores paranaenses; e os Novos Arranjos de Pesquisa e Inovação (Napi), que agrupam linhas de pesquisas, convergindo diferentes áreas do conhecimento.
“Esses três instrumentos possibilitam viabilizar os recursos financeiros e a inteligência, o que chamamos de smart money. O fomento não está relacionado apenas ao suporte financeiro. O que temos proposto é um novo modelo de mobilização que envolve a questão financeira, inteligência e articulação para obtermos a geração de riqueza e a qualidade de vida das pessoas, por meio da ciência, tecnologia e inovação”, explicou Spinosa.
Ao longo desta semana, a Secretaria da Ciência, Tecnologia e Ensino Superior (Seti) e a Fundação Araucária estão com espaços institucionais abertos ao público no pavilhão da 30ª Exposição de Ciência e Tecnologia (Expotec 2023). Simultaneamente, as sete universidades estaduais promovem projetos de ensino, pesquisa e extensão no pavilhão da SBPC Jovem.
- Estado lança Paraná faz Ciência 2023, evento dedicado à pesquisa e inovação
- Referência na certificação de produtos e sistemas, Tecpar passa marca de 20 mil auditorias
BIODIVERSIDADE – Uma pequena amostra do trabalho desenvolvido pelo Novo Arranjo de Pesquisa e Inovação (Napi Taxonline) chamou a atenção dos visitantes do espaço da Fundação Araucária. Esse Napi reúne 50 coleções biológicas das áreas da Botânica, Zoológica e Microbiológicas e mais de 230 espécies novas de grupos diversos que não eram conhecidas pela ciência, como insetos, bactérias, fungos, plantas, anelídeos, ascídias e peixes.
“As coleções científicas são importantes fontes de informação e em alguns casos a única fonte de informação da biodiversidade. As coleções biológicas são a base para qualquer estudo em biodiversidade e aplicação biotecnológica”, ressaltou Cristiano Marcondes Pereira, que atua como bolsista de Desenvolvimento Científico e Regional do Napi Taxonline. "Um dos papéis deste arranjo é tornar públicas essas informações, principalmente para os pesquisadores”.
POVOS INDÍGENAS – Também no evento, a Seti anunciou o XXIII Vestibular de Povos Indígenas do Paraná que será realizado em março de 2024. A iniciativa consiste em uma Política Pública de Estado amparada pela Lei nº 14.995/2006, que promove um vestibular específico para indígenas paranaenses para ingresso nas sete universidades estaduais e na Universidade Federal do Paraná (UFPR).
A coordenadora da Comissão Universidade para os Povos Indígenas (Cuia), professora Dulcinéia Galliano Pizza, da Universidade Estadual do Paraná (Unespar), salientou a importância do programa governamental para assegurar o acesso desse público à educação superior. “A ideia é que estudantes indígenas tenham a oportunidade de cursar qualquer curso superior com a mesma possibilidade de escolha e a mesma chance que outros candidatos”, afirmou.
INOVAÇÃO – No estande também foram apresentadas ações da Hotmilk, um ecossistema de inovação da Pontifícia Universidade Católica do Paraná (PUCPR), em Curitiba; e o Vale do Genoma, um ecossistema de inovação instalado em Guarapuava, na região Centro-Sul do Paraná, dedicado à pesquisa genética e inteligência artificial aplicadas à saúde. Ambas as iniciativas proporcionam ambientes propícios para o empreendedorismo e a inovação, engajando jovens pesquisadores na busca por soluções científicas e tecnológicas.
- Paraná articula nova parceria internacional para incentivar pesquisas de doutores
- Vírus, bactérias e fungos: UEL leva novos experimentos para a 75ª Reunião da SBPC
OUTRAS ATIVIDADES – Neste terceiro dia de evento foram realizadas várias reuniões estratégicas no estande do Sistema de Ciência, Tecnologia e Ensino Superior do Paraná. Os encontros reuniram representantes do Tribunal de Contas do Estado do Paraná (TCE-PR), do Conselho Regional de Engenharia e Agronomia do Paraná (Crea-PR), da Polícia Militar do Paraná (PMPR), da União Nacional dos Estudantes (UNE) e do Comitê Estadual do Programa de Estímulo às Ações de Integração Universidade, Empresa, Governo e Sociedade, denominado Agência de Desenvolvimento Regional Sustentável e de Inovação (Ageuni).
Também houve reuniões com os reitores das universidades estaduais do Paraná e os pró-reitores de Extensão e de Graduação das instituições. Na programação técnica, os professores Rodrigo Corrêa Gontijo e Maria Aparecida Fernandes, ambos da Universidade Estadual de Maringá (UEM), participaram de mesas-redondas sobre audiovisual e cinema e participação feminina na ciência, respectivamente.
Serviço:
Sistema Estadual de Ciência e Tecnologia e Ensino Superior do Paraná na 75ª Reunião Anual da SBPC
Local - Estandes nos pavilhões da Expotec 2023 e SBPC Jovem
Período - até 29 de julho
Local - Centro Politécnico da UFPR (entrada gratuita)